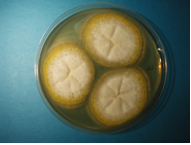

Mycotoxins: In Depth
This post has certainly been a long time coming. “Coming Soon” has been more like “Coming Soon ™”, but at long last, here it is.
We’ve got a lot of ground to cover, because there are a wide variety of mycotoxins out there and they have a wide variety of effects. Here’s a quick look at what we’ll discuss:
- What are Mycotoxins?
- Health Effects on Humans
- Health Effects on Livestock & Food Implications
- Common Mycotoxins
- Conclusion & References
Without further ado, we’ll jump right in!
1. What are Mycotoxins?
As far back as 800 B.C.E. the Romans prayed to Robigus, the god of agricultural disease, to protect their crops from mold and mildew. St. Andrew’s Fire, another name for Ergotism, a disease caused by eating crops contaminated with the mold Claviceps purpurea, is known to have had outbreaks as far back as 1129 in Paris. While the term ‘mycotoxin’ has only been around since 1962, and scientific research on mycotoxins began in earnest around that time, the effects of mycotoxins are visible throughout history.
All mycotoxins are produced by filamentous fungi, could cause disease or death in humans or other animals, and require only a small concentration to do so, but otherwise they have very little in common. In terms of chemical composition, toxicology, health effects, and so on, they are quite diverse. There are also lots of toxins produced by mold that are not considered mycotoxins. Bacteria-killing toxins produced by fungi are known as antibiotics. Phytotoxins are also produced by fungi, and primarily affect plants. Ethanol and similar compounds are not considered mycotoxins because a high concentration is required in order to be toxic. Depending on whose definition you care to use, there are between 300-400 known mycotoxin variants.
Not all mold produces mycotoxins. Not even all mold of a particular genus (or family) produce the same mycotoxins (or even mycotoxins at all!). Furthermore, the amount of mycotoxins produced even by a particular species of mold can vary widely, depending upon a number of factors including humidity, temperature, airflow, and stress factors.
2. Health Effects in Humans
When it comes to mycotoxin health effects, keep in mind that we aren’t physicians here at Moldlab. While we’ve tried to compile accurate and useful information here, it may not be complete, or it may not apply in your case. If you’re having health issues and believe it may be due to mycotoxin exposure, we strongly recommend you speak with your doctor. We’re certainly happy to help you any way we can, but we just aren’t qualified to talk beyond a certain point.
Another thing to keep in mind is that the effects of mycotoxin exposure are not very well understood. There is a distinct lack of conclusive evidence regarding the health effects of mycotoxin exposure. Controlled scientific studies simply haven’t been performed in this area, and until they are, all evidence is suggestive at best.
All of that out of the way, there are two broad categories of diseases caused by mold in humans. Mycoses are diseases caused by mold growing directly on or in humans. Mycotoxicoses are diseases caused by exposure to mold, but do not involve it growing on or in the victim. Most of the documented cases of mycotoxicoses are through ingestion of the mold spores in question. This is because the symptoms from ingesting mold tend to be much more severe than from merely inhaling it. Drying food supplies is important for this very reason; it helps to prevent the growth of toxic mold, which keeps the food suitable for use. Possible effects of ingesting a toxic mold include cancer, immune suppression, death, and many others.
The effects of inhaling mycotoxins tend to be less documented. There have been few studies on the effects of inhaling mold spores or mycotoxins. It is known that inhaling mold spores can cause mycoses, as in the case of Aspergillus fumigatus. Aspergillus fumigatus is a type of mold that can grow in the lungs of vulnerable individuals, causing a number of adverse health effects. Beyond that, there is little confirmed information. Mycotoxins are suspected of causing a wide variety of issues in both the short and long term- from headaches, allergies, and skin irritation to potential long-term affects such as cancer and immune suppression.
3. Health Effects on Livestock & Food Implications
Humans are not the only species effected by mycotoxin exposure. Many mycotoxins are toxic to a wide variety of plants and animals. Some toxins produced by mold may even be harmless to us, but toxic to other animals. The effects of ingesting mycotoxins are much better documented in animals than in humans. Livestock known to be effected by at least one type of mycotoxin include swine, poultry, dairy and beef cattle, and horses.
Ingestion of mold-contaminated feed is the most common means of exposure to mycotoxins in livestock. Once ingested, it causes a variety of observable effects. Different animals will be effected at different levels, and their exact symptoms vary. Generally, growth, productivity, and immune function are effected. Certain types of mycotoxins can be retained in livestock meat or other products. This means that contaminated animal feed, if undetected, could result in illness in humans eating the meat, milk, or eggs or affected animals.
Fortunately, screening for mycotoxin contamination in animal feed is a fairly common practice, and there are a wide variety of known methods of preventing contamination. Poor screening methods, lack of preventive measures, or a combination of both can still lead to mycotoxin exposure in animals.
4. Common Mycotoxins
Aflatoxin is probably the most well-known mycotoxin. They are produced by mold of the Aspergillus family- more specifically, Aspergillus flavus, Aspergillus parasiticus, and Aspergillus nomius. Human health effects include chronic diseases such as liver cancer. They may also lower fertility and cause birth defects. If ingested in sufficient quantity, aflatoxins can overwhelm the liver, which can cause acute liver failure.
Mycotoxins produced from mold of the Alternaria family are significantly less understood. It is possible that exposure to these mycotoxins causes esophageal cancer; however, the studies indicating this may have been flawed. Studies in animals have shown a wide variety of adverse health effects, including death.
Ciclosporin or Cyclosporine is a mycotoxin produced from Tolypocladium inflatum and Stachybotrys mold types. It is known to be carcinogenic, and is an FDA approved immunosuppressant.
Ochratoxin is a mycotoxin produced from Aspergillus ochraceus, Aspergillus carbonarius, and Penicillium verrucosum. There are two different types of Ochratoxin- A and B. The A variant is better studied. Exposure in humans commonly results in kidney toxicity. Exposure may also effect immune and neurological systems.
5. Conclusion
Well, if you read all that I’m definitely impressed! This was quite the long blog post, but we shouldn’t have any quite this long again for some time. If you have any questions about mycotoxins, feel free to leave a comment below and we’ll get back to you as
soon as we can. Alternatively, you can look into our source material below. Thanks for reading!
References:
https://www.ncbi.nlm.nih.gov/pmc/articles/PMC164220/
Click to access Understanding_mycotoxins.pdf
Click to access CPSCStatementmoldmycotoxinhealtheffectsJuly2015.pdf